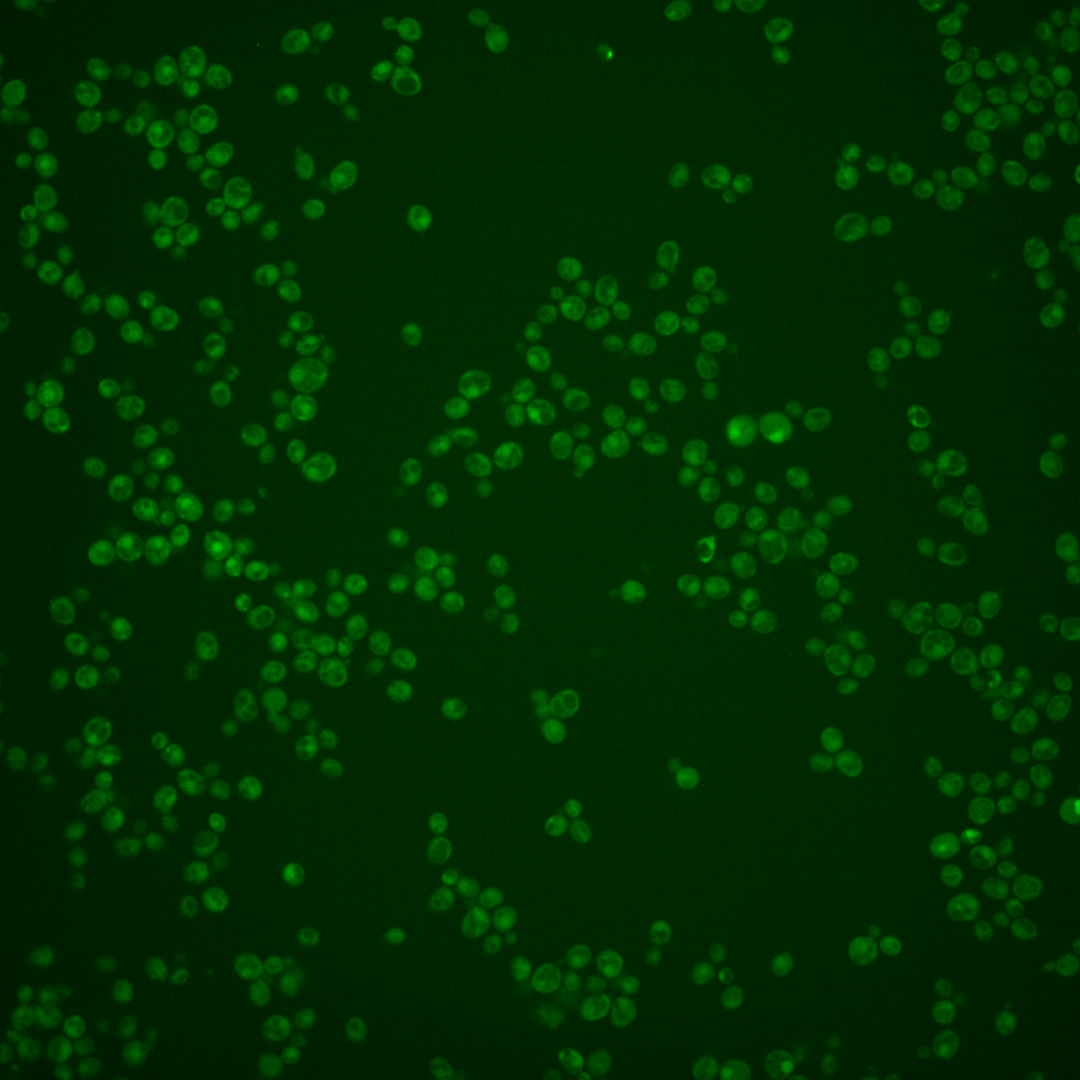
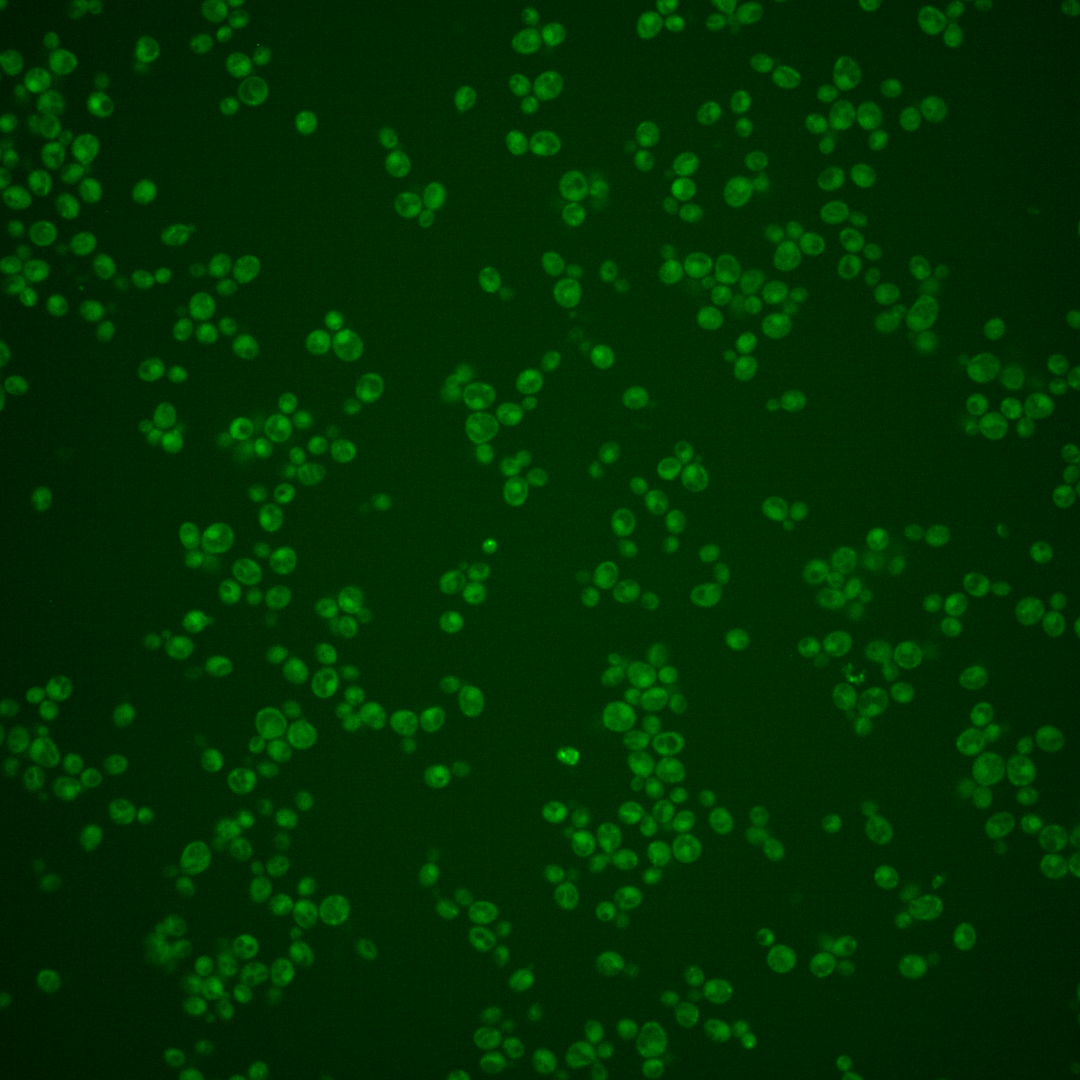

| Standard name | |
|---|---|
| Human Ortholog | |
| Description | High-affinity cysteine-specific transporter; has similarity to the Dal5p family of transporters; green fluorescent protein (GFP)-fusion protein localizes to the endoplasmic reticulum; YCT1 is not an essential gene |
Micrographs




















































































Sub-cellular Localization
Yeast GFP Assignment
Protein Abundance
Localization Change
External localization resources
| ensLOC | DeepLoc | |||||||||||||||||||||||
|---|---|---|---|---|---|---|---|---|---|---|---|---|---|---|---|---|---|---|---|---|---|---|---|---|
| Localization | WT1 | WT2 | WT3 | RAP60 | RAP140 | RAP220 | RAP300 | RAP380 | RAP460 | RAP540 | RAP620 | RAP700 | HU80 | HU120 | HU160 | rpd3Δ_1 | rpd3Δ_2 | rpd3Δ_3 | WT1 | WT2 | WT3 | AF100 | AF140 | AF180 |
| Cortical Patches | – | 0 | 0 | 0 | 0 | 0 | – | 0 | 0 | 0 | 0 | 0 | 3 | 3 | 0 | 0 | 0 | 0 | 0 | 0 | 17 | 9 | 11 | 12 |
| Bud | – | 0 | 0 | 2 | 3 | 7 | – | 16 | 31 | 15 | 30 | 38 | 3 | 3 | 0 | 0 | 0 | 1 | 0 | 0 | 11 | 3 | 10 | 17 |
| Bud Neck | – | 0 | 3 | 2 | 2 | 6 | – | 7 | 5 | 8 | 7 | 5 | 46 | 50 | 25 | 0 | 0 | 0 | 0 | 0 | 9 | 3 | 5 | 11 |
| Bud Site | – | 0 | 0 | 0 | 0 | 0 | – | 1 | 1 | 3 | 1 | 5 | 0 | 0 | 0 | 0 | 0 | 0 | – | – | – | – | – | – |
| Cell Periphery | – | 1 | 5 | 4 | 1 | 4 | – | 8 | 7 | 2 | 6 | 8 | 17 | 17 | 6 | 0 | 0 | 0 | 0 | 0 | 6 | 12 | 12 | 21 |
| Cytoplasm | – | 44 | 606 | 492 | 678 | 691 | – | 915 | 658 | 868 | 519 | 688 | 1317 | 1317 | 1323 | 68 | 183 | 117 | 19 | 51 | 317 | 364 | 456 | 635 |
| Endoplasmic Reticulum | – | 0 | 3 | 2 | 0 | 0 | – | 0 | 2 | 2 | 5 | 0 | 1 | 0 | 1 | 3 | 9 | 11 | 0 | 0 | 16 | 7 | 3 | 2 |
| Endosome | – | 0 | 4 | 5 | 24 | 8 | – | 21 | 11 | 13 | 11 | 7 | 1 | 1 | 0 | 0 | 3 | 3 | 0 | 0 | 20 | 1 | 2 | 3 |
| Golgi | – | 0 | 2 | 0 | 0 | 0 | – | 0 | 0 | 0 | 0 | 0 | 0 | 0 | 0 | 0 | 1 | 0 | 0 | 0 | 5 | 0 | 0 | 0 |
| Mitochondria | – | 5 | 5 | 12 | 36 | 171 | – | 143 | 292 | 383 | 312 | 339 | 0 | 0 | 0 | 4 | 4 | 4 | 2 | 2 | 130 | 65 | 59 | 59 |
| Nucleus | – | 0 | 1 | 0 | 1 | 1 | – | 2 | 2 | 2 | 5 | 8 | 2 | 2 | 2 | 11 | 8 | 3 | 0 | 0 | 1 | 0 | 0 | 1 |
| Nuclear Periphery | – | 0 | 0 | 0 | 0 | 1 | – | 2 | 1 | 2 | 3 | 6 | 0 | 0 | 0 | 0 | 1 | 0 | 0 | 0 | 0 | 0 | 1 | 0 |
| Nucleolus | – | 0 | 2 | 1 | 0 | 0 | – | 3 | 2 | 0 | 2 | 1 | 0 | 0 | 0 | 0 | 1 | 0 | 0 | 0 | 0 | 0 | 0 | 1 |
| Peroxisomes | – | 0 | 1 | 6 | 9 | 4 | – | 6 | 0 | 2 | 5 | 2 | 0 | 0 | 0 | 0 | 0 | 0 | 0 | 0 | 1 | 0 | 0 | 1 |
| SpindlePole | – | 0 | 5 | 3 | 18 | 12 | – | 39 | 45 | 46 | 26 | 30 | 3 | 3 | 1 | 0 | 0 | 0 | 0 | 0 | 7 | 7 | 10 | 15 |
| Vac/Vac Membrane | – | 0 | 4 | 4 | 12 | 15 | – | 20 | 17 | 28 | 15 | 31 | 2 | 3 | 0 | 19 | 72 | 51 | 0 | 5 | 48 | 9 | 10 | 8 |
| Unique Cell Count | 47 | 627 | 510 | 739 | 797 | 1081 | 898 | 1136 | 772 | 969 | 1328 | 1328 | 1324 | 88 | 238 | 155 | 24 | 65 | 613 | 502 | 602 | 817 | ||
| Labelled Cell Count | 50 | 641 | 533 | 784 | 920 | 1183 | 1074 | 1374 | 947 | 1168 | 1395 | 1399 | 1358 | 105 | 282 | 190 | 24 | 65 | 613 | 502 | 602 | 817 | ||
Yeast GFP Assignment
Protein Abundance
| Screen | WT1 | WT2 | WT3 | RAP60 | RAP140 | RAP220 | RAP300 | RAP380 | RAP460 | RAP540 | RAP620 | RAP700 | HU80 | HU120 | HU160 | rpd3Δ_1 | rpd3Δ_2 | rpd3Δ_3 | AF100 | AF140 | AF180 |
|---|---|---|---|---|---|---|---|---|---|---|---|---|---|---|---|---|---|---|---|---|---|
| Mean Cell GFP Intensity (1e-4) | – | 3.0 | 4.0 | 4.1 | 3.9 | 3.1 | – | 3.5 | 3.2 | 2.9 | 3.3 | 3.1 | 5.8 | 5.8 | 5.9 | 5.1 | 6.0 | 6.8 | 5.1 | 5.3 | 5.3 |
| Std Deviation (1e-4) | – | 0.4 | 1.4 | 1.9 | 1.7 | 1.1 | – | 1.3 | 1.2 | 0.9 | 1.2 | 1.0 | 0.9 | 0.9 | 0.9 | 1.2 | 1.5 | 1.8 | 1.3 | 1.2 | 1.4 |
| Intensity Change (Log2) | – | – | – | 0.06 | -0.01 | -0.34 | – | -0.17 | -0.31 | -0.44 | -0.27 | -0.38 | 0.55 | 0.55 | 0.58 | 0.35 | 0.59 | 0.77 | 0.36 | 0.41 | 0.42 |
Localization Change
| Localization | RAP60 | RAP140 | RAP220 | RAP300 | RAP380 | RAP460 | RAP540 | RAP620 | RAP700 | HU80 | HU120 | HU160 | rpd3Δ_1 | rpd3Δ_2 | rpd3Δ_3 |
|---|---|---|---|---|---|---|---|---|---|---|---|---|---|---|---|
| Actin | – | – | – | – | – | – | – | – | – | – | – | – | – | – | – |
| Bud | – | – | – | – | – | – | – | – | – | – | – | – | – | 0 | 0 |
| Bud Neck | – | – | – | – | – | – | – | – | – | – | – | – | – | 0 | 0 |
| Bud Site | – | – | – | – | – | – | – | – | – | – | – | – | – | 0 | 0 |
| Cell Periphery | – | – | – | – | – | – | – | – | – | – | – | – | – | 0 | 0 |
| Cyto | – | – | – | – | – | – | – | – | – | – | – | – | – | – | – |
| Endoplasmic Reticulum | – | – | – | – | – | – | – | – | – | – | – | – | – | 0 | 0 |
| Endosome | – | – | – | – | – | – | – | – | – | – | – | – | – | 0 | 0 |
| Golgi | – | – | – | – | – | – | – | – | – | – | – | – | – | 0 | 0 |
| Mitochondria | – | – | – | – | – | – | – | – | – | – | – | – | – | 0 | 0 |
| Nuclear Periphery | – | – | – | – | – | – | – | – | – | – | – | – | – | 0 | 0 |
| Nuc | – | – | – | – | – | – | – | – | – | – | – | – | – | – | – |
| Nucleolus | – | – | – | – | – | – | – | – | – | – | – | – | – | 0 | 0 |
| Peroxisomes | – | – | – | – | – | – | – | – | – | – | – | – | – | 0 | 0 |
| SpindlePole | – | – | – | – | – | – | – | – | – | – | – | – | – | 0 | 0 |
| Vac | – | – | – | – | – | – | – | – | – | – | – | – | – | – | – |
| Cortical Patches | – | – | – | – | – | – | – | – | – | – | – | – | – | 0 | 0 |
| Cytoplasm | – | – | – | – | – | – | – | – | – | – | – | – | – | 0 | 0 |
| Nucleus | – | – | – | – | – | – | – | – | – | – | – | – | – | 0 | 0 |
| Vacuole | – | – | – | – | – | – | – | – | – | – | – | – | – | 13.7 | 14.1 |
External localization resources
Images






























Protein Concentration and Protein Localization Data
| R1 | R2 | R3 | ||||||||||||||||
|---|---|---|---|---|---|---|---|---|---|---|---|---|---|---|---|---|---|---|
| G1 Pre-START | G1 Post-START | S/G2 | Metaphase | Anaphase | Telophase | G1 Pre-START | G1 Post-START | S/G2 | Metaphase | Anaphase | Telophase | G1 Pre-START | G1 Post-START | S/G2 | Metaphase | Anaphase | Telophase | |
| Concentration | 0.5026 | 0.5756 | 0.2708 | -0.1914 | 0.1908 | 0.4702 | -1.654 | -0.7481 | -1.1256 | -1.6637 | -1.8638 | -1.2195 | -2.5186 | -2.0213 | -2.3353 | -2.1022 | -2.5791 | -2.2207 |
| Actin | 0.013 | 0.0002 | 0.0004 | 0.0001 | 0.0009 | 0.0007 | 0.0001 | 0.0002 | 0.0005 | 0.0003 | 0.0005 | 0.0007 | 0.0204 | 0.0005 | 0.0011 | 0.0001 | 0.0001 | 0.0033 |
| Bud | 0.0009 | 0.0043 | 0.0023 | 0.0002 | 0.0006 | 0.0055 | 0 | 0 | 0.0001 | 0 | 0 | 0.0014 | 0.0002 | 0.0001 | 0.0003 | 0 | 0 | 0 |
| Bud Neck | 0.0027 | 0.0003 | 0.0002 | 0 | 0.0041 | 0.0007 | 0 | 0.0001 | 0 | 0 | 0.0001 | 0.0002 | 0.0074 | 0.0001 | 0.0001 | 0 | 0 | 0.0002 |
| Bud Periphery | 0.0026 | 0.0013 | 0.0018 | 0.0005 | 0.0005 | 0.0026 | 0 | 0 | 0.0001 | 0.0001 | 0.0001 | 0.0017 | 0.0006 | 0.0002 | 0.0013 | 0 | 0 | 0 |
| Bud Site | 0.0025 | 0.0117 | 0.0012 | 0.0001 | 0.0001 | 0.0002 | 0.0001 | 0.0003 | 0.0002 | 0 | 0.0001 | 0 | 0.0014 | 0.0004 | 0.0002 | 0 | 0 | 0.0001 |
| Cell Periphery | 0.0003 | 0.0005 | 0.0002 | 0 | 0 | 0.0002 | 0.0002 | 0.0001 | 0.0001 | 0 | 0.0001 | 0.0001 | 0.0006 | 0.0001 | 0.0003 | 0 | 0 | 0 |
| Cytoplasm | 0.0452 | 0.0711 | 0.0572 | 0.0807 | 0.0689 | 0.0835 | 0.1338 | 0.1343 | 0.0898 | 0.0556 | 0.1301 | 0.1449 | 0.0365 | 0.0804 | 0.0708 | 0.0509 | 0.0887 | 0.1553 |
| Cytoplasmic Foci | 0.0147 | 0.0091 | 0.0086 | 0.0071 | 0.0093 | 0.0125 | 0.0069 | 0.0047 | 0.0094 | 0.0042 | 0.0061 | 0.0051 | 0.0095 | 0.0075 | 0.0092 | 0.0051 | 0.013 | 0.0063 |
| Eisosomes | 0.0004 | 0.0001 | 0.0002 | 0 | 0.0002 | 0.0001 | 0.0003 | 0.0002 | 0.0006 | 0.0001 | 0.0001 | 0.0001 | 0.0006 | 0.0001 | 0.0001 | 0.0001 | 0.0001 | 0 |
| Endoplasmic Reticulum | 0.0102 | 0.003 | 0.002 | 0.0011 | 0.001 | 0.0011 | 0.0106 | 0.0018 | 0.0016 | 0.0013 | 0.0015 | 0.0085 | 0.0148 | 0.0064 | 0.0036 | 0.0007 | 0.0006 | 0.0008 |
| Endosome | 0.0079 | 0.0071 | 0.0046 | 0.0019 | 0.0003 | 0.0026 | 0.004 | 0.0022 | 0.0041 | 0.0014 | 0.0007 | 0.0013 | 0.006 | 0.0017 | 0.0059 | 0.0007 | 0.0003 | 0.0074 |
| Golgi | 0.0013 | 0.0001 | 0.0001 | 0.0001 | 0.0001 | 0.0001 | 0.0002 | 0.0001 | 0.0002 | 0.0001 | 0.0001 | 0.0001 | 0.0013 | 0.0003 | 0.0002 | 0 | 0 | 0.0007 |
| Lipid Particles | 0.0032 | 0.0005 | 0.0003 | 0.0001 | 0.0002 | 0.0003 | 0.0056 | 0.0005 | 0.0006 | 0.0004 | 0.0006 | 0.0002 | 0.0032 | 0.0124 | 0.0006 | 0.0006 | 0.0003 | 0.0008 |
| Mitochondria | 0.0016 | 0.0004 | 0.0011 | 0.0003 | 0.0003 | 0.0003 | 0.0001 | 0.0001 | 0.0002 | 0.0002 | 0.0002 | 0.0005 | 0.0009 | 0.0008 | 0.0003 | 0.0001 | 0.0001 | 0.0001 |
| None | 0.8731 | 0.8675 | 0.9033 | 0.9054 | 0.9022 | 0.8727 | 0.8322 | 0.8523 | 0.8892 | 0.9347 | 0.8571 | 0.8327 | 0.8774 | 0.8836 | 0.902 | 0.9398 | 0.8957 | 0.8173 |
| Nuclear Periphery | 0.0085 | 0.0033 | 0.0016 | 0.0003 | 0.0004 | 0.0006 | 0.002 | 0.0005 | 0.0004 | 0.0004 | 0.0004 | 0.0004 | 0.0058 | 0.0019 | 0.0009 | 0.0004 | 0.0002 | 0.0015 |
| Nucleolus | 0.0006 | 0.0004 | 0.001 | 0.0001 | 0.0005 | 0.0004 | 0.0001 | 0.0001 | 0.0001 | 0.0001 | 0.0001 | 0.0001 | 0.0014 | 0.0002 | 0.0001 | 0.0001 | 0 | 0.0001 |
| Nucleus | 0.0024 | 0.0027 | 0.0027 | 0.0004 | 0.0009 | 0.0021 | 0.0008 | 0.0004 | 0.0003 | 0.0003 | 0.0008 | 0.0004 | 0.0047 | 0.0006 | 0.0006 | 0.0003 | 0.0001 | 0.0003 |
| Peroxisomes | 0.0027 | 0.0002 | 0.0002 | 0.0001 | 0.0004 | 0.0001 | 0.0001 | 0 | 0.0003 | 0.0001 | 0.0003 | 0.0003 | 0.0013 | 0.0008 | 0.0001 | 0.0001 | 0.0001 | 0.0001 |
| Punctate Nuclear | 0.0031 | 0.0012 | 0.0072 | 0.0003 | 0.0087 | 0.0071 | 0.0005 | 0.0004 | 0.0008 | 0.0004 | 0.0005 | 0.0006 | 0.004 | 0.0009 | 0.0006 | 0.0005 | 0.0004 | 0.0008 |
| Vacuole | 0.0019 | 0.0142 | 0.0034 | 0.0011 | 0.0002 | 0.0061 | 0.0021 | 0.0016 | 0.0013 | 0.0002 | 0.0004 | 0.0007 | 0.0014 | 0.0008 | 0.0014 | 0.0005 | 0.0002 | 0.0045 |
| Vacuole Periphery | 0.001 | 0.0007 | 0.0006 | 0.0001 | 0 | 0.0005 | 0.0001 | 0.0001 | 0.0001 | 0.0001 | 0 | 0.0001 | 0.0006 | 0.0003 | 0.0003 | 0.0001 | 0 | 0.0003 |
Sequencing Data
| R1 | R2 | |||||||||
|---|---|---|---|---|---|---|---|---|---|---|
| G1 Post-START | S/G2 | Metaphase | Anaphase | Telophase | G1 Post-START | S/G2 | Metaphase | Anaphase | Telophase | |
| Gene Expression | 3.1111 | 1.2361 | 1.3758 | 4.6895 | 3.1373 | 6.2188 | 4.3742 | 5.0611 | 4.6232 | 6.4323 |
| Translational Efficiency | – | – | – | – | – | – | – | – | – | – |
Hit Data
| Dataset | Hit |
|---|---|
| Protein Concentration | ✘ |
| Protein Localization | ✘ |
| Gene Expression | ✘ |
| Translational Efficiency | – |
Endocytosis
| Temp | Actin Patch (Sac6-tdTomato) | Cortical Patch (Sla1-GFP) | Late Endosome (Snf7-GFP) | Vacuole (Vph1-GFP) |
|---|---|---|---|---|
| 37℃ | ||||
| RT |
Cell Cycle Omics
CYCLoPs (Yct1-GFP)
| Gene / Allele | Actin Patch (Sac6-tdTomato) | Cortical Patch (Sla1-GFP) | Late Endosome (Snf7-GFP) | Vacuole (Sac6-tdTomato) |
|---|
| Gene | Images |
|---|
| Gene | Images |
|---|
Images are not yet available
Images are not yet available